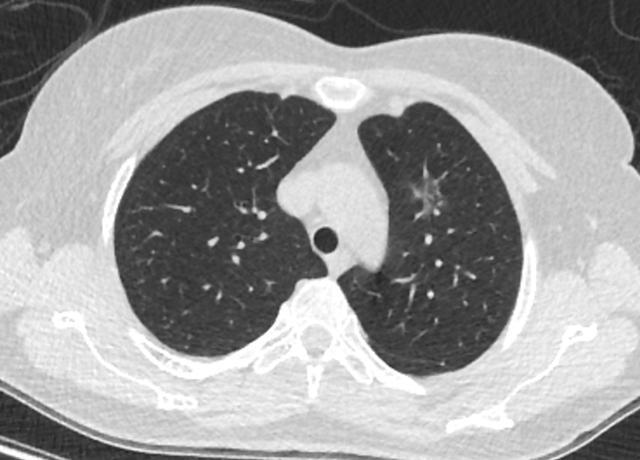

肺磨玻璃结节可以随访多久?
肺磨玻璃结节可以随访多久?
科普目录:
一、为什么原来没听说过肺磨玻璃结节?
二、肺磨玻璃结节认识现状?
三、随访16年的肺磨玻璃患者现状?
四、磨玻璃结节是肺癌吗?
五、磨玻璃结节需要尽快手术吗?
六、磨玻璃结节可以消融吗?
七、作者简介

双肺在体内的大概位置
一、为什么原来没听说过肺磨玻璃结节?
——不管你看没看见,它一直就在那里!
磨玻璃结节就像其他任何疾病一样,估计从人类诞生就一直有,但是为什么原来没有听说过呢?磨玻璃结节拍片、透视是很难发现的;1971-2002年CT主要是单层CT,层厚比较厚10mm为主,一些小的磨玻璃很容易漏掉;2003年发明了16排螺旋CT以后,CT扫描的所有图像都是1mm左右的薄层了,这时候人们才开始慢慢发现磨玻璃结节;2010年左右人们开始注解关注并研究磨玻璃结节,所以说肺磨玻璃结节是古老的疾病,全新的认识。

二、肺磨玻璃结节认识现状?
——人类对疾病的认识一直在变化之中
2011年美国完成的一项研究—低剂量螺旋CT肺癌筛查可以降低肺癌死亡率的20%;这时候全世界才开始逐渐认识并研究肺结节;国内是上海研究的比较早,并且对磨玻璃结节认识比较充分;之后由南方逐渐向北方普及肺癌筛查,肺结节的认识也逐渐提高,但是平均下来,国内精通肺结节的医生凤毛麟角,了解肺结节的医生估计不到整体医生数量的1%,所以目前医生、患者得到的磨玻璃结节的信息是不全面的、建议也未必是规范的。

永恒的只有变化
三、随访16年的肺磨玻璃患者现状?
——不能让患者活的更长、活的更好的治疗都是不恰当的。
女,现67岁,发现肺磨玻璃结节16年,2004年偶然发现肺结节,由于各种原因,一直随访中。
图1、2004年

图2、3 2008年1月10日


图4 2015年4月29日
图5、6 2020年5月15日


漫长的16年,一个纯磨玻璃结节从原位腺癌缓慢正常到浸润性腺癌早期阶段(影像估测),所以说纯磨玻璃结节是不可怕的,可以安心随访,到合适的时机手术完全来得及,不要上来动不动就手术,动不动就消融!
混合磨玻璃结节和实性结节的生长规律与纯磨玻璃结节不同,不能套用这个模式。
四、磨玻璃结节是肺癌吗?
—— 磨玻璃结节有良性、恶性之分
虽然长期随访持续存在的磨玻璃结节恶性几率高,但是它最大的优点是恶性程度低,治愈率高到不可想象!不像我们原来常听说的肺癌那么可怕!
良性的磨玻璃例如局灶性肺炎、出血、纤维化等,无需治疗!
“恶性”范畴的不典型腺瘤样增生(无需治疗)、原位腺癌(部分需要治疗治愈率100%、部分只需观察)、
恶性的微浸润腺癌(大部分需要手术,治愈率≈100%)、浸润性腺癌(以磨玻璃为主的,治愈率>90%)。

混合磨玻璃结节
五、磨玻璃结节需要尽快手术吗?
单发的磨玻璃结节,如果到了原位腺癌阶段,部分需要手术,到了微浸润腺癌的阶段建议手术,到了浸润性腺癌早期阶段一定手术。
多发的磨玻璃结节,慎重手术,因为病灶生长缓慢,我们不知道未来哪个结节先生长到威胁我们健康的时候,所以建议到了微浸润及以上,再根据病灶的生长位置,再决定如何手术,一次性手术切除几个病灶等,由胸外科和影像科共同做出规划。

不同阶段的多源发磨玻璃状肺腺癌
六、磨玻璃结节可以消融吗?
消融治疗,是最近几年发展起来的微创治疗方法,具有良好的效果,但是一定要注意适应症和禁忌症,不所有的结节都适合消融治疗。



七、作者简介:

解耀锃(xie yao zeng)
聊城市第二人民医院—早期肺癌筛查科主任。
CFDA“中国人工智能肺结节标准数据库”仲裁组专家。
山东省医学影像大数据及人工智能学组委员。
擅长肺结节、肺肿瘤、肺癌的影像诊断。2000年本科毕业于长治医学院-医学影像系;一直从事CT诊断工作,2015年起专职研究肺结节影像诊断及诊疗方案。
在国内较早成立了专业科室——早期肺癌筛查科。开设了肺结节影像门诊、肺癌多学科门诊,为肺结节、肺肿瘤、肺癌患者提供了筛查、诊断、治疗一站式医疗服务。
GE低剂量CT肺癌筛查培训示范基地。
推想、医准“肺结节智能识别系统”临床应用医院。
多次受邀在国家级、省级学术会议上介绍“早期肺癌LDCT筛查”;被誉为中国基层医院早期肺癌筛查拓荒者。
-

- 今天,别人忙着做堂食,炳胜老板为什么还在推外卖?
-
2025-04-15 05:49:07
-

- 建议:床板就选排骨架的,不是误导,是床的使用要求所决定
-
2025-04-15 05:46:52
-

- 桂林山水,一张中国名片
-
2025-04-15 05:44:37
-

- 2月7日周三丨新闻速览
-
2025-04-15 05:42:23
-

- 最悲不过英雄迟暮――辛弃疾晚年两首怀古词
-
2025-04-15 05:40:09
-

- 什么是感知?感知就是存在
-
2025-04-15 05:37:56
-

- 被低估的一届?11年选秀前十重排:欧文下滑变榜眼,巴特勒升探花
-
2025-04-14 23:08:46
-

- 院校解读 之 华南师范大学
-
2025-04-14 23:06:31
-

- 忒修斯之船 * 哲思
-
2025-04-14 23:04:17
-
- [大案纪实]魏振海:身负11条人命,枪决时仰天大笑?
-
2025-04-14 23:02:03
-

- 天主教、基督新教和东正教究竟有什么区别?
-
2025-04-14 22:59:48
-

- 商丘市第一高级中学
-
2025-04-14 22:57:34
-

- 太原青龙古镇|30元游乐套票全攻略,一票畅玩古镇7大主题
-
2025-04-14 22:55:19
-

- 日本孝谦天皇风流成性,在位时口碑极差,爱过表哥宠过和尚
-
2025-04-14 22:53:05
-

- 多肉马库斯真皮实,夏天不休眠,好养好看长成群生肉墩子
-
2025-04-14 22:50:51
-

- 游记:春节去香港吃喝玩乐行程“解剖”(附上叮叮车路线图)
-
2025-04-14 22:48:36
-

- 湘北明珠一一津市
-
2025-04-14 22:46:23
-

- 刘德华发型又酷又帅,蓬松又整齐更有男人味,喜欢油头的男生试试
-
2025-04-14 16:30:03
-

- 10部不同类型的灾难片,每一部都堪称经典
-
2025-04-14 16:27:49
-
- 权臣一不高兴就被打,朝代只他一个皇帝,十一岁登基的皇帝元善见
-
2025-04-14 16:25:34



 一条烟不开封可以放多久?
一条烟不开封可以放多久? 彭冠英张含韵被曝结婚:低调的幸福爱情婚姻,或许与她的经历有关
彭冠英张含韵被曝结婚:低调的幸福爱情婚姻,或许与她的经历有关 王治郅的妻子周蕾,身材高挑 才貌双全 照片欣赏
王治郅的妻子周蕾,身材高挑 才貌双全 照片欣赏 范冰冰不雅图片 范爷大尺度裸身戏遭曝光
范冰冰不雅图片 范爷大尺度裸身戏遭曝光 扎西顿珠视为信仰的宗庸卓玛与平凡丈夫的爱情,七年卧床不离不弃
扎西顿珠视为信仰的宗庸卓玛与平凡丈夫的爱情,七年卧床不离不弃 中国著名相声演员姜昆简历
中国著名相声演员姜昆简历